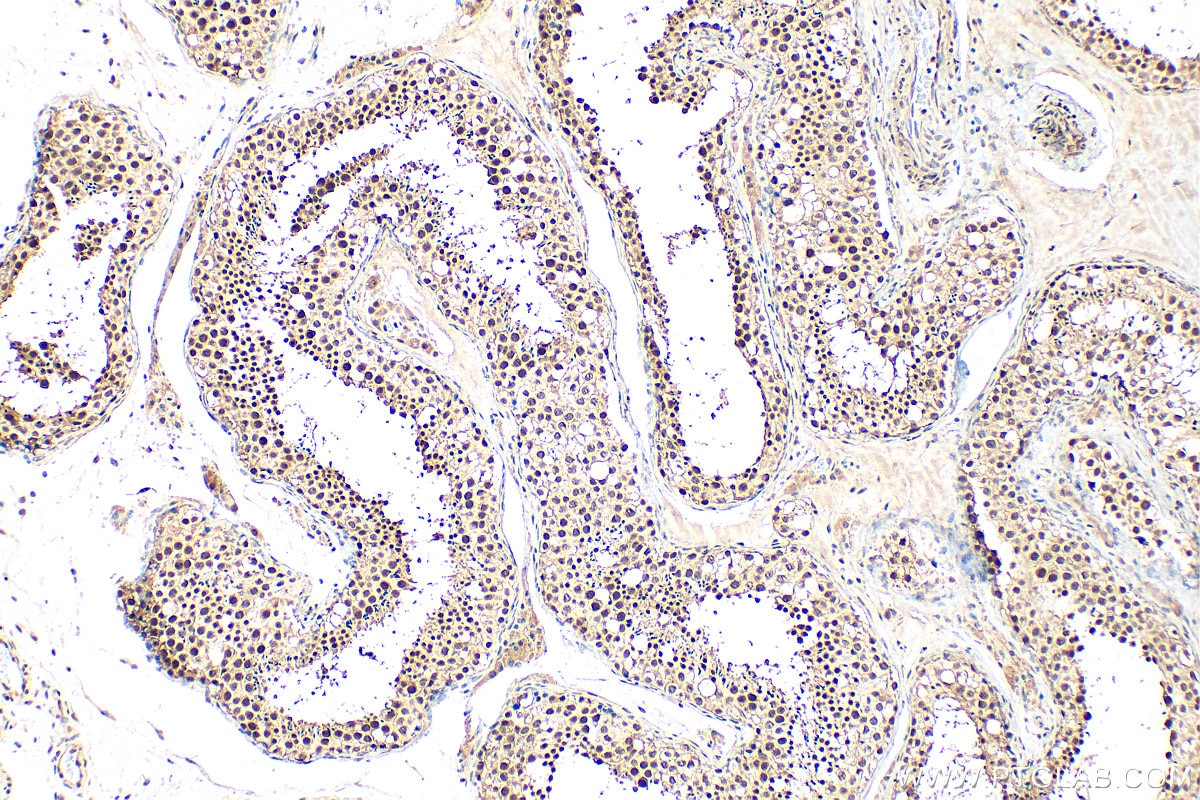
IHC staining of human testis using 13665-1-AP Immunohistochemistry (IHC) staining of human testis tissue using CTNNBL1 Polyclonal antibody (13665-1-AP)

Tested Applications
| Positive WB detected in | Jurkat cells, mouse spleen tissue, mouse thymus tissue |
| Positive IHC detected in | human testis tissue Note: suggested antigen retrieval with TE buffer pH 9.0; (*) Alternatively, antigen retrieval may be performed with citrate buffer pH 6.0 |
Recommended dilution
| Application | Dilution |
|---|---|
| Western Blot (WB) | WB : 1:500-1:1000 |
| Immunohistochemistry (IHC) | IHC : 1:50-1:500 |
| It is recommended that this reagent should be titrated in each testing system to obtain optimal results. | |
| Sample-dependent, Check data in validation data gallery. | |
Published Applications
| WB | See 2 publications below |
Product Information
13665-1-AP targets CTNNBL1 in WB, IHC, ELISA applications and shows reactivity with human, mouse samples.
| Tested Reactivity | human, mouse |
| Cited Reactivity | human |
| Host / Isotype | Rabbit / IgG |
| Class | Polyclonal |
| Type | Antibody |
| Immunogen |
CatNo: Ag4578 Product name: Recombinant human CTNNBL1 protein Source: e coli.-derived, PGEX-4T Tag: GST Domain: 1-308 aa of BC036739 Sequence: DANKLYCSEVLAILLQDNDENRELLGELDGIDVLLQQLSVFKRHNPSTAEEQEMMENLFDSLCSCLMLSSNRERFLKGEGLQLMNLMLREKKISRSSALKVLDHAMIGPEGTDNCHKFVDILGLRTIFPLFMKSPRKIKKVGTTEKEHEEHVCSILASLLRNLRGQQRTRLLNKFTENDSEKVDRLMELHFKYLGAMQVADKKIEGEKHDMVRRGEIIDNDTEEEFYLRRLDAGLFVLQHICYIMAEICNANVPQIRQRVHQILNMRGSSIKIVRHIIKEYAENIGDGRSPEFRENEQKRILGLLENF Predict reactive species |
| Full Name | catenin, beta like 1 |
| Calculated Molecular Weight | 563 aa, 65 kDa |
| Observed Molecular Weight | 65 kDa |
| GenBank Accession Number | BC036739 |
| Gene Symbol | CTNNBL1 |
| Gene ID (NCBI) | 56259 |
| RRID | AB_2086245 |
| Conjugate | Unconjugated |
| Form | Liquid |
| Purification Method | Antigen affinity purification |
| UNIPROT ID | Q8WYA6 |
| Storage Buffer | PBS with 0.02% sodium azide and 50% glycerol, pH 7.3. |
| Storage Conditions | Store at -20°C. Stable for one year after shipment. Aliquoting is unnecessary for -20oC storage. 20ul sizes contain 0.1% BSA. |
Background Information
CTNNBL1, also named as C20orf33, belongs to the armadillo-containing protein family (PMID: 32484799). CTNNBL1 is a widely expressed nucleoprotein that associates with the pre-mRNA processing factor 19 (Prp19) complex of the spliceosome, interacting with its CDC5L component. CTNNBL1 can maintain the content and integrity of the Prp19 spliceosome complex by regulating the interaction between CWC15 and CDC5L (PMID: 28501461). CTNNBL1 has 4 isoforms with the molecular weights of 36, 43, 62 and 65 kDa, respectively. CTNNBL1 may play an important role in colorectal cancer and regulating AID function (PMID: 28501461, 32484799).
Protocols
| Product Specific Protocols | |
|---|---|
| IHC protocol for CTNNBL1 antibody 13665-1-AP | Download protocol |
| WB protocol for CTNNBL1 antibody 13665-1-AP | Download protocol |
| Standard Protocols | |
|---|---|
| Click here to view our Standard Protocols |
Publications
| Species | Application | Title |
|---|---|---|
J Transl Med eIF6 promotes the malignant progression of human hepatocellular carcinoma via the mTOR signaling pathway. |